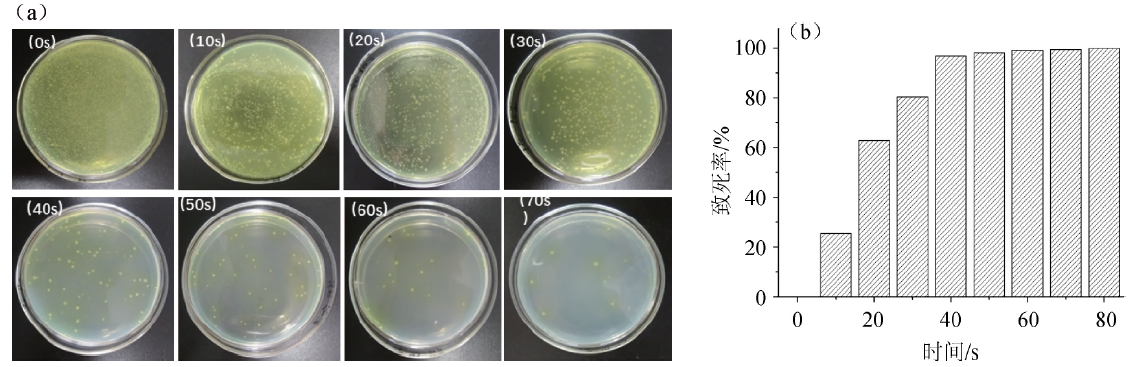

常压室温等离子体诱变与微生物微滴培养选育几丁质脱乙酰基酶高产菌株
来源: 作者: 发布时间:2020-09-22 15:46 浏览量:212
本期为您推荐天津科技大学生物工程学院工业发酵微生物教育部重点实验室王敏教授研究团队与洛阳华清天木生物科技有限公司联合发表在《中国酿造》上的一篇文章:常压室温等离子体诱变与微生物微滴培养选育几丁质脱乙酰基酶高产菌株。
文章摘要内容如下:
几丁质是自然界中仅次于纤维素的第二大生物聚合物,壳聚糖是几丁质脱掉乙酰基的产物,比几丁质具有更大的商业应用价值。目前壳聚糖主要采用传统化学法生产,存在环境污染严重、工艺难控制、产品质量特别是脱乙酰度不稳定等问题。采用几丁质脱乙酰基酶(CDA)酶法脱乙酰制备壳聚糖越来越受到人们的重视。但目前该工艺还无法实现产业化应用,所以高产CDA的菌株筛选仍然是解决CDA应用的主要途径之一。
本研究将常压室温等离子(atmospheric and room temperature plasma,ARTP)诱变与微生物微滴培养(microbial microdroplet-culture,MMC)技术应用于几丁质脱乙酰基酶(CDA)高产菌株的诱变选育,构建高产CDA菌株的诱变及高通量筛选方法。结果表明,经过4轮的ARTP诱变及MMC筛选,从200个不同的液滴中共筛选出5个发酵产酶明显提升的液滴,并通过进一步的平板筛选、24-深孔板复筛,获得了17株产酶提高300%以上的诱变菌株。通过对比分析17株高产菌株产CDA的能力,确定了1株最佳CDA高产菌株B4,其CDA最大产量比出发菌株提高了3.15倍,发酵产酶总量达到419.11U/mL,为原始菌种的3.90倍。
常压室温等离子体(ARTP)诱变技术是一种高效的微生物育种技术,微生物微滴培养(MMC)技术是基于液滴微流控技术最新研发而成的一款微生物培养系统,是一种基于微流控技术的微型化、自动化、智能化的高通量微生物培养,具有高通量、自动传代、化学因子梯度添加、在线检测液滴光谱、微生物分选等功能。ARTP目前已经高效应用于多种细菌、真菌以及植物种子等的诱变选育,但鲜有将ARTP应用于CDA发酵菌株的诱变选育,同时,MMC也是首次被应用于CDA高产菌株的高通量筛选。本研究提供了一种新的CDA高通量筛选方法,为CDA高产菌株的诱变选育以及其他可通过显色反应进行菌株筛选的工作提供了借鉴。
文章精彩内容如下:

图1 常压室温等离子体+微流控对高产ReCDA菌株的诱变选育流程
图2 常压室温等离子体不同诱变时间对马红球菌CGMCC14861生长(a)及致死率(b)的影响

图3 马红球菌CGMCC14861的微生物微滴培养结果

图5 菌株B4摇瓶培养产几丁质脱乙酰基酶曲线
